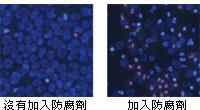
化妝、護膚品有害成大搜查

為了追求美麗,都會用上護膚品和化妝品,但是美麗的表面暗藏危機。現在有很多產品為了強加產品效果,都會在產品裡加強化學物質成分,有的甚至加入有害成分,這些成分可能包含毒性及致癌物,大家選購時一定要小心留意。
很多時候,我們使用一些產品後會出現致敏反應,如水楊酸、果酸一類的產品;一些人使用內含防腐劑及有害化學成分的護膚品,皮膚會即時變得敏感、泛紅和痕癢,但大部分人的皮膚並不會產生即時敏感,反而是在使用了一段時間後,化學成分慢慢累積、滲透,才對皮膚造成傷害,所以一般人並不察覺自己所用的護膚品有問題。
事實上,有研究結果顯示,長期使用含防腐劑成分產品,會令皮膚細胞加速老化及變得脆弱。一種產品中所加入的防腐劑雖然只屬微量,但是大家每日所使用的護膚品不會只得一種……一早一晚合共使用的護膚品及化妝品加起來隨時多達 6 種,當中有害化學成分加起來所造成的傷害,實在非同小可,絕對是「慢性傷害」。
為了保障消費者,化妝及護膚品上需要清楚列明產品產地、製造日期、保質日期、開封後保存期、全成分的標示等,在購買化妝品、護膚產品前,要先留意一下產品包裝盒上的成分表,了解清楚所使用的護膚品當中含有哪些成分,做個精明消費者。
常見於化妝、護膚品的 4 大有害成分:防腐劑、礦物油、香料、人造色素

防腐劑
成份名稱:Parabens (如 ethyl-, methyl-, propyl-parabens)
對皮膚的影響:
1. 形成不健全的角質層,使皮膚粗糙、黯淡,防禦力下降。
2. 加速細胞老化,令皮膚漸漸失去彈性,容易產生鬆弛、細紋。
3. 損傷細胞 DNA
4. 與美白、抗老化成分相抵觸
5. 在角質層中積聚,令以上問題加深

如果想更快查詢你所使用的產品的成份,可以到以下的網站查詢:COSDN
或者使用 Think Dirty App: Think Dirty:用app check下你用的化妝護膚品有無毒
資料來源: FANCL、網上資料